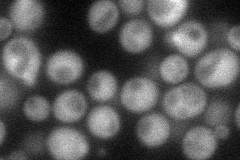
YNR008W
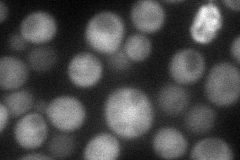
YNR008W
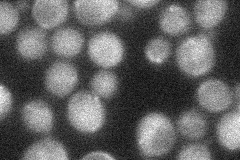
YNR008W
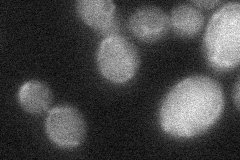
YNR008W
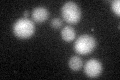
YNR008W

View description
Acyltransferase that catalyzes diacylglycerol esterification; one of several acyltransferases that contribute to triglyceride synthesis; putative homolog of human lecithin cholesterol acyltransferase
Localization:
Intensity:
Fold change:
Significance:
-
C’ GFP library in SD

below threshold17.4 -
N' NOP1pr-GFP in SD
cytosol60.1213 -
N' TEF2pr-mCherry in SD
cytosol59.3643 -
N' NATIVEpr-GFP in SD
cytosol27.4707 -
N' TEF2pr-VC and Cyto-VN in SD
below threshold25.9599 -
C’ GFP library in SD+DTT
cytosol19.491.11No -
C’ GFP library in SD+H2O2

cytosol21.821.25No -
C’ GFP library in Starvation Media

cytosol15.70.9No -
C’ GFP library on the background of Pup2-DaMP

below threshold -
C’ GFP library on the background of CCT mutant

below threshold19.02111.09244No
